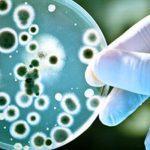

Tinubu says Nigeria ‘ll take advantage of global demand in lithium to develop more processing plants

Nigeria Government says it is working towards taking advantage of the global demand for lithium by developing more processing plants in states that are rich in lithium deposits.
The federal government however extended an invitation to potential investors to take advantage of the investment opportunities and incentives available in all sectors to improve the county’s economy.
President Bola Ahmed Tinubu, who stated this at the 2024 Nasarawa Investments Summit, held at the Aliyu Akwe’s Banquet hall in Lafia, urged other states to emulate Nasarawa, by intensifying efforts to attract investments to their respective states.
According to the President, “Lithium is the future and the future is very electrifying. Manufacturers have continued to produce cars and trucks powered by batteries, rather than fossil fuel.
“Therefore, we as a country must prepare for this, by ensuring we take full advantage of the global demand in lithium by developing more processing plants in Nasarawa and across other states that are rich in lithium and in Nigeria as a whole, while also sustainably developing our lithium deposits,” he said.
Doris Uzuka Anite, the Minister of Trade and Investment, who stood in for the President, reiterated the passion of Tinubu’s administration for industrial development in the country.
He said the support of the President in seeing states and subnationals, who are rising like Nasarawa State to woo investors would be sustained.
Tinubu noted, that the 2024 summit, themed Industrial Renaissance is a summit that marks a significant milestone in Nasarawa’s journey towards economic transformation.
“Industrial renaissance is not just a theme, but a call for action. It is a recognition that our industries are backbone of our economy, and that we must revitalize and reinvigorate them to drive the growth and development of our Nation”.
He said, that Nasarawa being a home of solid minerals, has immense potential for industrial growth, with its strategic location for natural resources and skilled workforce.
The president, therefore commended Governor Abdullahi Sule for creating a viable industrial ecosystem that attracts investment, creates jobs and stimulates innovations, saying that, the efforts that foster a friendly business environment, investment in infrastructure, promoting value addition in key sectors, such as agriculture, morning and energy should be sustained.
Tinubu recounted that the launch of a 4,000 tons per day lithium processing plant is a testament to its allure for Investment.
This, according to the president, underscores the state’s reputation as an investment destination and its dedication to providing an enabling business environment.
He said the initiative as the summit is pivotal in showcasing the vast opportunities awaiting investors across all sectors of Nigeria’s economy.
He added that the vast lithium deposit is to be developed and processed and ensure raw materials are not exported out of the country, without any value addition, in line with the renewed hope agenda of his administration.
President Tinubu emphatically said that “as far as solid mineral development is concerned, Nasarawa State remains the envy of other state in the country.
Governor Abdullahi Sule, who acknowledged the commitment of investors and partners, said that their presence in the state “offers us the opportunity to continue to map the future of our state as far as the economic landscape is concerned, as the future remains ours and we are relentless when it comes to Nasarawa State”.
Governor Sule recalled that the outcome of the 2022 summit, with the theme “Diamond in the Rough”, “informed the influx of so many investors that are coming to the state”.
“The recently Commissioned Avatar new energy company limited, Azgat Mining and Processing Plant in Karu, Nasarawa Technology Village among others are investments, as result of the 2022 summit.”
The governor stressed that the discovery of oil hydrocarbon and its subsequent exploitation and exploration will further boost the economic prosperity of the country, and out the state among the committee of oil-producing states in the country.
He particularly called on investors in the oil and gas to show more interest in the oil and gas activities in the state.
To ensure full utilization of our potential, Governor Sule said, “we have pledge to sustain the investment summit to further showcase solid mineral resources, which are yet to be identified by interested parties”, hence the 2024 theme, industrial renaissance.
He was optimistic that, the summit will further expand the state’s existing pathway to leveraging on the industrial, agriculture and mining sectors, towards enhancing inclusive and sustainable wealth creation and economic prosperity.
The governor was sure that, with the assemblage of investors and business executives at the summit, it is believed that, the outcome will go a long way towards actualizing our dreams of industrializing the state and positioning it as a leading champion in the country.
Earlier, the Chief Executive Officer and Managing Director, of Nasarawa State Investment and Development Agency, Abdullahi Ibrahim, said the journey so far was a result of the bold step taken and vision, which started 5 years ago.
The NASIDA Boss, who enumerated its policy direction, said the reforms initiated laid the foundation for the Nasarawa Investment Summit and a driving force for the state industrialization and vision.
He said, that since the summit in 2022, the Agency has recorded remarkable progress across sectors, which included the increase and steady flow of IGR, the launch of Nasarawa Technology Village, expansion and setting up of a premium marble processing plant, Nasarawa agro commodity project, Saro Africa sugar project and soon to be launched Green Ville CNG hub in the state for North Central region among other multiple development partners have been attracted to the state.
Ibrahim said the 2024 summit was built on the foundation, aimed to attract more investments, cultural irrigation and to solidify the state as a leading industrial hub in Nigeria.
Leave a Comment